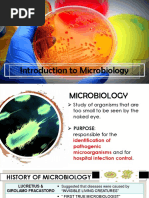

Assignment on Forensic Science
Forensic Science
Definition: The study of evidence discovered at a crime scene and used in a court of law. Forensic science is
any science used for the purposes of the law, and therefore provides impartial scientific evidence for use in
the courts of law, and in a criminal investigation and trial. Forensic science is a multidisciplinary subject,
drawing principally from chemistry and biology, but also from physics, geology, psychology, social science,
etc.
Forensic science is the process of using science to resolve legal issues. This is done by applying scientific
principles to matters in which the law has become involved. Forensic science is becoming more and more
common place in crime scene investigation and other fields and forensic technology continues to evolve.
There are a lot of different fields in which a forensic scientist can put their education to use.
The job of a forensic scientist is to fold, despite what many people think. The first job is to analyze physical
evidence and the second task is to share this information through written word or even through epert
testimony in a court of law.
Fields of Forensic Science
!ecause many cannot define forensic science they assume that people who do this for a living are only into
crime scene investigation. "hile that is a huge area for forensic science, it is not the only area. There are
many different fields that involve forensic science including and not limited to:
a. Forensic #nthropology which is the study of the human body and social relationships
b. Forensic $hemistry which is the study of properties of matter
c. Forensic %ntomology is the study of bugs
d. Forensic &athematics is the process of finding patterns between crime scenes and evidence
e. Forensic 'ursing can involve helping survivors of crimes such as rape and assault
f. Forensic (dontology is the study of the development and abnormalities found in teeth
g. Forensic )econstruction is the process of recreating a crime scene to provide factual testimony
h. Forensic Technology is the process of solving crimes with advanced technology
i. Forensic Toicology involves the study of poisons or toins
*atent +rint ,dentification: ,dentifying objects such as fingerprints, palm prints, even foot prints or shoe
prints #s you can see, there are many areas of study when you go into forensic science. "hile many of these
jobs can be criminal in nature, meaning to help solve crimes, these careers can get very specific to a certain
niche of the forensic science world that interests you most. &any people start out with a very generalized
job and then they get more focused the more they learn and work.
The Importance of Forensic Science
Forensic science is interwoven into the way that things are done today. "ithout forensic science we
wouldn-t have a lot of the knowledge that we currently have about crimes that have been committed,
fingerprints, poisons, the human body, bugs, relationships, and so much more. Forensic science not only
allows for us to learn more and eplore our world in new and fascinating ways, it helps us to make the world
we live in a much safer place.
Fields of Forensic Science
!ecause many cannot define forensic science they assume that people who do this for a living are only into
crime scene investigation. "hile that is a huge area for forensic science, it is not the only area. There are
many different fields that involve forensic science including and not limited to:
a. Forensic #nthropology which is the study of the human body and social relationships
b. Forensic $hemistry which is the study of properties of matter
c. Forensic %ntomology is the study of bugs
d. Forensic &athematics is the process of finding patterns between crime scenes and evidence
e. Forensic 'ursing can involve helping survivors of crimes such as rape and assault
f. Forensic (dontology is the study of the development and abnormalities found in teeth
g. Forensic )econstruction is the process of recreating a crime scene to provide factual testimony
h. Forensic Technology is the process of solving crimes with advanced technology
i. Forensic Toicology involves the study of poisons or toins
*atent +rint ,dentification: ,dentifying objects such as fingerprints, palm prints, even foot prints or shoe
prints #s you can see, there are many areas of study when you go into forensic science. "hile many of these
jobs can be criminal in nature, meaning to help solve crimes, these careers can get very specific to a certain
niche of the forensic science world that interests you most. &any people start out with a very generalized
job and then they get more focused the more they learn and work.
Fingerprint
,n humans, the surface of the palms of the hands and the fingers, and the soles of the feet and the toes, are
covered with a special type of thickened skin known as friction ridge skin. This has evolved in primates to
provide a gripping surface and also, through the greater concentration of nerve endings present, to facilitate
an enhanced sense of touch. #s the name suggests, friction ridge skin has a ridged appearance, rather like
that of a ploughed field in miniature, with furrows separating the individual ridges. .owever, these ridges
are not arranged in straight lines but form comple patterns on the surface of the skin. $ontact between an
area of friction ridge skin and another surface may result in the creation of a characteristic print or
impression on that surface /0ection 1.2.13. Furthermore, a set of prints, for eample of the fingers and
thumbs, can be reproduced deliberately using inks or similar substances to produce a permanent record.
0uch prints can be used as a means of personal identification that is based on the following premises:
The fingerprints of an individual stay unchanged throughout life. The friction ridge pattern of an
individual is fully formed in the fetus by about 41 weeks after conception. The eact arrangement of
the ridges is determined by the dermal papillae, a layer of cells that separates the outer layer of skin
/the epidermis3 from the underlying dermis. This pattern endures throughout life, although it may be
marred, for eample, by deep scarring. &oreover, it persists for some time after death and may
therefore prove useful in post5mortem identification.
'o two fingerprints are identical. 0upport for this principle came first from 0ir Francis 6alton-s
theoretical calculations presented in his landmark publication, Finger prints, in 2784. ,n this, he
demonstrated that the odds against two individual fingerprints being eactly the same were 91 billion
to 2. +erhaps even more compelling is the actual evidence accrued from fingerprinting individuals
over the past 2:: years. (f the many millions classified to date, no two fingerprints have yet been
found to be the same, even those of identical twins.
The presence of recognizable ridge pattern types has allowed
fingerprints to be systematically classified. The fingerprint
classification system adopted in most %nglish5speaking
countries /including %ngland and "ales from 28:23 was the
.enry 0ystem. This 2:5print classification system was
developed by 0ir %dward )ichard .enry /27;:<28=23, based
on the observations made by 0ir Francis 6alton /2744<28223
of three basic types of fingerprint patterns loops,
arches and whorls. %ach of these three types, and their
subtypes, are described below:
Loops
#pproimately 9: per cent of all fingerprints fall into the loop pattern category,
making it the commonest of the three basic types. ,n this pattern, at least one ridge
must enter from one side, curve around and then eit at the same side. Two
subtypes are recognized < the radial loop and the ulnar loop< depending on the
direction of flow of the ridges. ,n simple terms, if the loop opens in the direction of
the thumb /i.e. towards the radial bone of the forearm3, it is termed a radial loop
and if it opens in the direction of the little finger /i.e. towards the ulnar bone of the
forearm3 it is known as an ulnar loop.
To be classified as a true loop pattern, all of the four features listed below must be present:
a single delta /an area where the ridges diverge3>
a core /the pattern-s centre3>
a minimum of one recurving ridge that flows between the delta and the core>
a minimum ridge count of one.
Arches
The arch pattern accounts for about ; per cent of all fingerprint patterns. Two
subtypes are recognized: the plain arch and the tented arch .,n the plain arch,
which is the simplest fingerprint pattern of all, the friction ridges flow from one
side to the other rising smoothly in the centre, like a wave? ,n contrast, the
tented arch, which may be considered as an intermediate between an arch and a
loop, usually has either a central up thrusting ridge or ridges meeting at an angle
of 8:@ or less at the ape of the arch. .owever, as may be epected, there are
also tented arches that show some, but not all, of the four characteristics of the
loop pattern.
Whorls
The whorl pattern accounts for about =; per cent of all fingerprint patterns. The
situation regarding the classification of whorl patterns based on the .enry
0ystem is complicated because different ways of subdividing whorl patterns are
used. (ne categorization that is in common usage, and is recognized by the
Federal !ureau of ,nvestigation /F!,3, places whorls into the following four
types < plain, central pocket loop, double loop and accidental. The simplest of
these is the plain whorl, which has two deltas and a minimum of one ridge that
completely encircles the core, describing the shape of a circle, oval or spiral in
so doing. ,f an imaginary line connecting the two deltas encounters at least one
ridge circling the core, then the pattern belongs to the plain whorl subtype.
.owever, if it does not, the pattern is distinguished as a central pocket loop
whorl # more complicated whorl pattern is the double loop whorl, which consists of two loop patterns in
combination. This third type is known in the
AB as the twinned loop. The fourth and final
subtype, the accidental whorl, is applied to
fingerprints either that consist of a
combination of two or more pattern types
/with the eception of the plain arch3 or
whose pattern does not fit into any of the
recognized categories previously described.
The different types fingerprint
Fingerprints recovered at an incident scene can usually be placed into one of the three categories outlined
below, although sometimes the distinction is a fine one. #s such fingerprints are normally transient in nature,
categorization into type enables them to be Cuickly and appropriately processed.
Latent Fingerprint
*atent fingerprints cannot be seen with the naked eye. They consist mainly of perspiration euded from the
sweat pores, which occur in single rows along the ridges of the friction ridge skin. +erspiration is composed
mainly of water /D8; per cent3 with the remaining ; per cent made up of other substances such as salt and
amino acids. 0omebody oil or grease may also be present in latent fingerprints, transferred to the fingertips
by touching other parts of the body such as the hair. *atent prints reCuire visualization before identification.
The chemicals used in their development react with the different chemicals present in the perspiration. ,n
some instances, negative latent fingerprints may be formed when an individual touches a surface that is
either covered in dust, for eample, or sticky for some reason.
Visible fingerprints
#s the name suggests, this type of fingerprint contrasts well with its substrate and is therefore easily visible
to the naked eye. Eisible fingerprints are formed when an appropriate substance is transferred by the
fingertips onto a suitable surface. %amples of such materials are paint, blood, grease, ink, faces, cosmetic
materials and soot. ,t should be noted that the nature of the surface upon which a print is deposited might be
the only factor that determines whether a print is classified as latent or visible.
Plastic Fingerprints
The third type of fingerprint does not involve the deposition of substances, visible or otherwise, onto a
surface but is formed when a negative ridge impression is made into some suitably soft material. These are
known as plastic fingerprints and may be found, for eample, in fresh paint, clay, soap, candle wa,
chocolate or putty. !eing three dimensional, they are often reasonably visible to the naked eye.
Collection & Preservation of Fingerprint
Fingerprint evidence left behind by a suspect or victim may identify who was at a crime scene and what he
or she touched. .owever, it is important for defense attorneys to know, and to inform the jury, that the
techniCues used to locate and identify fingerprints are far from a perfect science. #n understanding of how
fingerprints are located and lifted can help attorneys recognize if a flawed analysis was performed by
investigators or lab technicians. Further, knowledge of the various fingerprint collection techniCues is
essential to successful cross5eamination of crime scene technicians and fingerprint eaminers. This post
attempts to provide an overview of the techniCues used to locate, lift, and identify a fingerprint.
Locating the fingerprint
*ocating a fingerprint often reCuires a vigilant and calculated search. .owever, in circumstances where the
print is visible to the naked eye, finding a fingerprint is relatively easy. The more intricate searches take
place when the print is present on a surface but not visible. The type of fingerprint left behind usually
determines the amount of time and effort investigators must put into locating the print.
#ccording to Forensic 0cience, there are three types of fingerprints. D.+. *yle, Forensic 0cience /#!#
Fundamentals3, p. 4;; /4:243:
+atent prints are easy to locate since they are visible to the naked eye. +atent prints occur when
someone has a substance on their fingers such as grease, paint, blood, or ink that leaves a visible
print on a surface.
+lastic prints are also easy to locate but are less common than patent prints since they occur when
someone touches an object such as wa, butter, or soap and leaves a three5dimensional impression of
the finger on the object.
*atent prints are the most common type of print and take the most effort to locate since they are
invisible. *atent prints occur when someone touches any porous or nonporous surface. The natural
oils and residue on fingers leave a deposit on surfaces which mirror the ridges and furrows that are
present on the individual-s finger.
Photographing the fingerprint
#fter the print is located, it is vital that it is photographed before it is lifted. # photograph captures where the
print was located in comparison to other objects and captures the orientation of the print. Further, a
photograph can serve as a key piece of identification of a patent or plastic print and can be used to compare
and possibly match the print to its source. +hotographing the print-s location at the crime scene also guards
against tampering of evidence. 0ee 0cientific %vidence by +aul $. 6iannelli p. 89159;.
Lifting the fingerprint
F*ifting a fingerprintG means to make a permanent impression of the fingerprint. *ifting a print can be
accomplished on either flat surfaces or round surfaces. *ifting a print usually involves a rubber tape with an
adhesive surface which is applied to the fingerprint, leaving an imprint on the tape. (ften times, a flat object,
such as a ruler, will be slowly swiped across the top of the tape to ensure that there are no bubbles or ripples
in the tape that will affect the imprint. 'et, the tape is carefully peeled off the surface and a plastic cover is
placed on the adhesive side of the tape to prevent disruption of the print. ,dentification information and a
description of the location of the print should be written on the back of the tape or card. ,d. at 89H597.
#fter the print is lifted, it is converted into digital data that can be modified to create a clearer image.
omparing the fingerprint
The final step involves a close eamination of the characteristics of the fingerprints.
# system called the #utomated Fingerprint ,dentification 0ystem /#F,03 was created to find a match
to the print using a computer database.
Footprint
Forensic footwear marks analysis has the potential to link an item of footwear with a forensic footwear mark
recovered from a crime scene or from the skin of a victim.
Forensic footprint analysis 5undertaken by our forensic footwear eperts includes the comparison of crime
scene footprints with control marks made by
footwear taken from the suspect. This can
uniCuely link or eliminate a suspect, or provide
supporting forensic evidence where a
categorical opinion is not possible.
Type of Footwear Impression
Two!dimensional footwear impression
This type of impression is made when the under sole of a shoe encounters a hard, flat surface such as a
linoleum floor or a counter top. ,n many cases, material is transferred from the sole of the shoe and
deposited on the substrate. These are known as positive impressions and include those made with wet mud
or blood. +ositive impressions are usually readily visible, at least in the initial stages before the material
adhering to the sole wears off and the prints become latent /i.e. invisible to the naked eye3. *ess freCuently,
two5dimensional impressions are made by the removal of residual material from a flat surface, thus creating
negative footwear impressions. These may occur, for eample, when impressions are made in dust or on a
surface covered with a thin film of wa polish.
Three!dimensional footwear impression
This type of footwear impression is formed when the shoe is impressed into a soft, plastic material such as
earth, sand or snow. #s is the case with two5dimensional footprints, these are initially photographed at the
crime scene in order to obtain a permanent record. They are then preserved, if possible, by taking casts.
+laster of +aris and dental stone are both used for casting three5dimensional footwear impressions.
Collection & Preservation of Footprint
Impression
#lthough impression evidence is etremely fragile, if left undisturbed it can remain for long periods of time.
#s long as a crime scene area isnIt harmed by weather /mainly wind, rain and snow3 or disturbance from
other shoes, tires or tools, there are two major techniCues eperts use to gather impression evidence:
Latent "two!dimensional# impressions 5 *atent impression recovery is very similar to basic
fingerprinting. This techniCue is used for difficult5to5preserve, two5dimensional impressions on
materials such as tile floors, wood floors or chairs. +owder is applied with a brush to make the print
more visible, and then tape or a lifting machine records a visual of the impression.
asting 5 To recover larger, three5dimensional impressions such as tire marks or footprints left in
muddy conditions, eperts use casting. The process works in very much the same way as an
orthodontist makes a model of a patientIs teeth: # substance is poured into the impression, hardened,
and then removed, providing a cast of the print on the ground. ,nvestigators use a variety of products
to create casts, but dental stone, in fact, is widely considered the best casting material due to its
strength, accuracy and ease of use.
Tool5&arks
Tool marks are freCuently present at crime scenes, particularly when the crime is one of burglary. 0uch
marks or impressions may provide evidence that can, on
occasion, lead to the positive identification of a tool, and, by
association, to the identity of a suspect. %ven when a suspect
tool is not available, tool marks left at one crime scene may be
found to match those found at others, thus establishing a vital
intelligence link between separate crimes. 0ome eamples of
tool marks are: slashed tires by knife, indented hammer strikes
on door, pried open window, cut wires or fencing, severed
chains and picked locks.
J # tool mar$ is any impression, cut, gouge, or
abrasion caused by a tool coming in contact with another object.
# Ftool markG can be caused by an endless list of objects:
J # screwdriver is most often used to tighten or loosen screws. .owever, if it is used to pry
open a widow it will leave impressions ,n the window sill.
J $ar tires leave impressions in the ground.
J %ven a button on your shirt will leave an impression on your skin if pressed hard enough.
,n general tool marks reveal class characteristics, such as size and shape of tool used. .owever, once a tool
has been used minute random markings on the surface can impart individual characteristics to objects
Collection & preservation of tool-marks
Preser%ation and Pac$aging of Tools
#ll areas on recovered tools which contain transferred paint, building material, or other
contamination should be wrapped in paper and packaged to prevent the prying blades or cutting
edges .
&a$e 'o Tests With Tools
#ttempts should never be made to fit tools into Cuestioned marks or to make test marks prior to
*aboratory eamination. ,f done, the Cuestioned mark or tool may be altered and this may make any
*aboratory eamination valueless. ,n addition, traces of transferred paint or other stains on the tool
may be lost or additional material may be transferred to the tool.
Preser%ation of Tool &ar$s
"henever possible, submit the whole object containing tool marks to the *aboratory instead of just
removing the area containing the mark. ,f this is not possible, carefully photograph and sketch the
area containing the mark. #lthough this photograph will not be sufficient to allow the *aboratory to
perform a tool mark comparison with the tool, it will assist the *aboratory to determine how the
mark was made so that test marks can be5more easily made.
$asts of tool marks can be made by a person who has had considerable eperience in this work. +oor
casts are useless for comparison purposes and some marks will be damaged if improper methods are
used.
+ack the object containing tool marks so that no alteration or damage will occur during shipment.
0mall objects should be wrapped with clean paper and placed in envelopes or boes, while important
areas on larger objects can be protected with paper. "hole, large objects can be packed in cartons or
crates, if not delivered in person.
Document Examination
# document may be broadly defined as anything that bears marks, signs, or symbols which have meaning or
conveys a message to someone.
Scope of (oc)ment *+amination
,dentification of handwriting and
signatures
,dentification of a document as a
forgery
,dentification of typewriters, check
writers, and photocopies
Detection of alterations, additions, deletions, or substitutions
Deciphering alterations and erasures
,dentification and deciphering of indented writing
$omparisons of inks and identification of type of writing instrument
,andwriting Identification
.andwriting identification is based on the principle that, while handwriting within a language tends to be
alike to the degree that we can meaningfully read it, there are individual features that distinguish one
personIs writing from that of another. Kust as no two people are eactly alike, the handwritings of no two
people are eactly alike in their combination of characteristics. There are, of course, natural variations
within the handwriting of each individual. These variations must be closely and carefully studied by the
eaminer, so that he can distinguish between what is a LvariationL and what is a LdifferenceL.
The eaminer must also be cognizant of the differences between Lclass characteristicsL and Lindividual
characteristicsL. $lass characteristics are those which are common to a group such as a particular writing
system, family grouping, foreign language system, or professional group. ,ndividual characteristics are
those which are personal or peculiar letters or letter combinations, which, taken together, would not occur in
the writing of another person.
Forgery
!elow are the classes of forgery commonly encountered:
'o attempt is made by the forger to imitate the genuine signature of the person purportedly signing
the document.
There is an attempt to imitate the genuine signature by some method of tracing of a model signature.
There is a freehand attempt to simulate the genuine signature from a model.
The document and the purported signer are fictitious.
# Lcut M pasteL job wherein a genuine signature, or copy thereof, is transferred from some authentic
source to a fraudulent document.
Collection & preservation of Question document
-)estioned &aterial to be S)bmitted
#ll Cuestioned documents involved in a particular investigation should be submitted to the *aboratory for
eamination. This is important since Cuestioned documents are identified by a comparison of similarities,
plus an absence of divergences or dissimilarities. ,n order to make an identification, sufficient handwriting,
typewriting, or other evidence must be available on which to base an opinion.
*+emplars
,t is very important to have sufficient handwriting eemplars for comparison with the Cuestioned document.
(ne or two signatures on a suspectIs driverIs license or a draft card, in many cases, does not contain
sufficient individual characteristics on which to base a conclusion. ,n some instances, such an eamination
may substantiate a suspicion and this should be considered as an investigational lead. To support this, it is
necessary to obtain and eamine additional standards.
Preser%ation of -)estioned (oc)ments
Ander no circumstances should either the Cuestioned document or the eemplars be marked, defaced,
or altered. 'o new folds should be made, nor should marks or notes be placed on such material.
+ersonal marks for identification purposes should be made as small as possible on the back or other
area of the document where no handwriting or typewriting is present.
"henever possible, all documents should be protected by placing them in cellophane or plastic
envelopes.
Shipment of *%idence
Nuestioned documents may be submitted personally or left in previously described lockers at the
*aboratory entrance.
0uch evidence sent to the *aboratory by mail must be sent by certified or registered mail. ,f there is a
massive amount of material, it may be sent some other way, but the package must always be sealed.
harred (oc)ments
"here eamination and decipherment of charred paper is involved, great care must be taken to prevent any
additional crumbling or breaking apart of the burned material. 'ormally it should be placed on top of loose
cotton in a bo and delivered in person to the *aboratory. 'o matter how it is packaged, such material will
be damaged if attempts are made to ship it by mail.